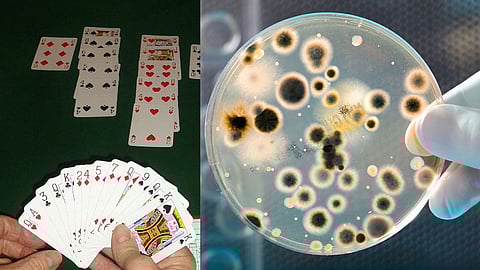

ربطت السلطات الصحية، التي تحقق في أول حالة وفاة مؤكدة ناتجة عن فيروس كورونا في ولاية كولورادو، الحالة بمسابقة للعبة «البريدج»، التي تستخدم فيها أوراق اللعب، بمقاطعة إل باسو.
وكانت الضحية، وهي امرأة تبلغ من العمر 80 عامًا تعاني أمراضًا مزمنة، شاركت في مسابقة بمركز كولورادو سبرينجز بريدج خلال الفترة من 27 فبراير إلى 3 مارس. وتم الإعلان عن وفاتها في 13 مارس.
وحددت السلطات، خلال بحثها عن أي أفراد معرضين للخطر، منافسات ألعاب محددة تم تنظيمها في المركز، وفقًا لوكالة أنباء بلومبرج.
وقال كيمبرلي باتيسون المسؤول الصحي في مقاطعة «إل باسو» في بيان: نحن قلقون للغاية بشأن احتمال انتقال المرض خلال المسابقة وفي المجتمعات بعد عودة المتنافسين إلى منازلهم.
وارتفع إجمالي حالات الإصابة المؤكدة بفيروس كورونا في ولاية كولورادو، أمس السبت، إلى 101 شخص، من أصل 711 شخصًا تم إجراء اختبارات لهم، وفقًا لإدارة الصحة العامة والبيئة في كولورادو.